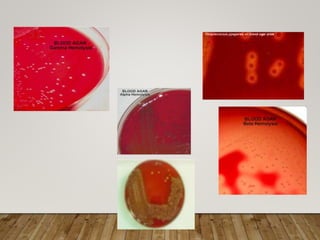
31
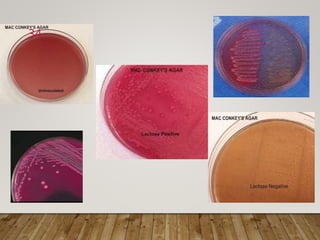
34
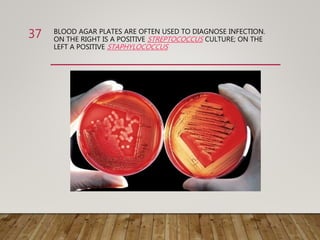
BLOOD AGAR PLATES ARE OFTEN USED TO DIAGNOSE INFECTION.
ON THE RIGHT IS A POSITIVE STREPTOCOCCUS CULTURE; ON THE
LEFT A POSITIVE STAPHYLOCOCCUS
37
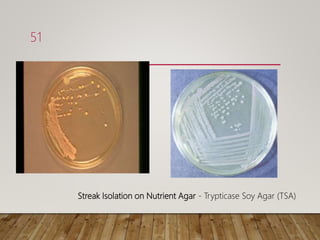
Streak Isolation on Nutrient Agar - Trypticase Soy Agar (TSA)
51
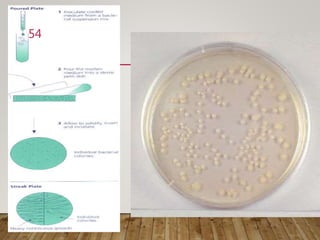
54
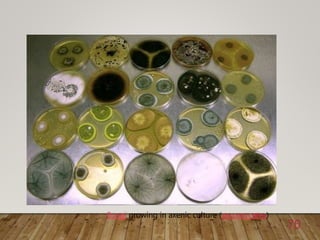
Fungi growing in axenic culture (ascomycetes)
70

The document describes microbial cultivation, emphasizing the process of growing microorganisms in artificial laboratory environments, which requires specific nutritional conditions and media types. It outlines the characteristics and types of culture media, including solid, liquid, and semisolid forms, alongside their uses for isolation, identification, and growth of bacteria. Various techniques for obtaining pure cultures, such as streak plate and pour plate methods, are also discussed to highlight the importance of maintaining sterility and accurately isolating particular bacterial species.